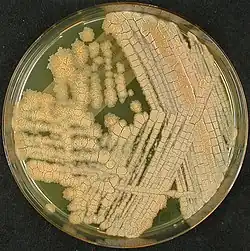

Tsukamurella inchonensis
| Tsukamurella inchonensis | ||
|---|---|---|
![]() Tsukamurella inchonensis | ||
| Taxonomía | ||
| Dominio: | Bacteria | |
| Reino: | Bacillati | |
| Filo: | Actinomycetota | |
| Clase: | Actinomycetes | |
| Orden: | Mycobacteriales | |
| Familia: | Tsukamurellaceae | |
| Género: | Tsukamurella | |
| Especie: |
Tsukamurella inchonensis Yassin et al. 1995 | |
Tsukamurella inchonensis es una bacteria grampositiva del género Tsukamurella. Fue descrita en el año 1995. Su etimología hace referencia a la región de Sinchon, en Corea del Sur. Es aerobia. En Löwenstein-Jensen crecen colonias entre marrón y anaranjado, rugosas. Temperatura de crecimiento entre 24-45 °C. Se aisló a partir de varios hemocultivos de un paciente con bacteriemia tras ingestión de ácido hidroclórico y de un tejido pulmonar de un paciente con un tumor necrótico en el pulmón.[1] En el primer caso, la vía de entrada posiblemente fue mediante un catéter tras varios días de hospitalización del paciente.[2]
Clínica
Después de su descripción, se ha aislado en más casos de infección en el torrente sanguíneo mediante catéter, tanto en un paciente inmunodeprimido,[3] en un niño con linfoma de Hodgkin[4] y en un paciente con embolismo séptico pulmonar.[5]
Beneficios
Hay estudios que han mostrado que esta especie tiene efecto inmunoterapéutico en el desarrollo de hiperplasia miointimal en ratas y en diabetes mellitus tipo 2 también en ratas.[6][7] Además, algunos estudios sugieren que su uso en la alimentación de truchas arcoíris (Oncorhynchus mykiss) y de pollos tiene un beneficio en su crecimiento, sistema inmunitario y estructura intestinal.[8][9]
Hábitat
Existen unos pocos aislamientos ambientales de esta especie, principalmente en aguas.[10]
Referencias
- ↑ Yassin, A. F.; Rainey, F. A.; Brzezinka, H.; Burghardt, J.; Lee, H. J.; Schaal, K. P. (1995-07). «Tsukamurella inchonensis sp. nov». International Journal of Systematic Bacteriology 45 (3): 522-527. ISSN 0020-7713. PMID 8590680. doi:10.1099/00207713-45-3-522. Consultado el 13 de agosto de 2022.
- ↑ Chong, Y.; Lee, K.; Chon, C. Y.; Kim, M. J.; Kwon, O. H.; Lee, H. J. (1997-06). «Tsukamurella inchonensis bacteremia in a patient who ingested Hydrochloric acid». Clinical Infectious Diseases: An Official Publication of the Infectious Diseases Society of America 24 (6): 1267-1268. ISSN 1058-4838. PMID 9195101. doi:10.1093/clinids/24.6.1267. Consultado el 13 de agosto de 2022.
- ↑ Takebe, Isao; Sawabe, Etsuko; Ohkusu, Kiyofumi; Tojo, Naoko; Tohda, Shuji (2014-06). «Catheter-related bloodstream infection by Tsukamurella inchonensis in an immunocompromised patient». Journal of Clinical Microbiology 52 (6): 2251-2253. ISSN 1098-660X. PMC 4042780. PMID 24671800. doi:10.1128/JCM.00421-14. Consultado el 13 de agosto de 2022.
- ↑ Ochi, Fumihiro; Tauchi, Hisamichi; Moritani, Kyoko; Miyamoto, Hitoshi; Ohkusu, Kiyofumi; Ishii, Eiichi (2015). «Tsukamurella inchonensis infection in a child with Hodgkin's lymphoma». Pediatrics International: Official Journal of the Japan Pediatric Society 57 (1): e7-10. ISSN 1442-200X. PMID 25711272. doi:10.1111/ped.12472. Consultado el 13 de agosto de 2022.
- ↑ Gotoh, Kazuyoshi; Mayura, I. Putu Bayu; Hagiya, Hideharu; Obata, Kyoichi; Ogawa, Tatsuo; Iio, Koji; Fujimori, Takumi; Otsuka, Fumio et al. (2021-02). «Septic pulmonary emboli caused by Tsukamurella inchonensis: A case report». Journal of Infection and Chemotherapy: Official Journal of the Japan Society of Chemotherapy 27 (2): 369-372. ISSN 1437-7780. PMID 33036892. doi:10.1016/j.jiac.2020.09.024. Consultado el 13 de agosto de 2022.
- ↑ Hansrani, Monica; Stanford, John; McIntyre, Graham; Bottasso, Oscar; Stansby, Gerard (2010-07). «Immunotherapy for the prevention of myointimal hyperplasia after experimental balloon injury of the rat carotid artery». Angiology 61 (5): 437-442. ISSN 1940-1574. PMID 20498142. doi:10.1177/0003319710366128. Consultado el 13 de agosto de 2022.
- ↑ Tarrés, María Cristina; Gayol, María Del Carmen; Picena, Juan Carlos; Alet, Nicolás; Bottasso, Oscar; McIntyre, Graham; Stanford, Cynthia; Stanford, John (2012-05). «Beneficial effects of immunotherapy with extracts derived from Actinomycetales on rats with spontaneous obesity and diabetes». Immunotherapy 4 (5): 487-497. ISSN 1750-7448. PMID 22642332. doi:10.2217/imt.12.37. Consultado el 13 de agosto de 2022.
- ↑ Nofouzi, Katayoon; Sheikhzadeh, Najmeh; Varshoie, Hossein; Sharabyani, Sona Khadir; Jafarnezhad, Mehran; Shabanzadeh, Sadigheh; Ahmadifar, Ehsan; Stanford, John et al. (2019-02). «Beneficial effects of killed Tsukamurella inchonensis on rainbow trout (Oncorhynchus mykiss) growth, intestinal histology, immunological, and biochemical parameters». Fish Physiology and Biochemistry 45 (1): 209-217. ISSN 1573-5168. PMID 30178124. doi:10.1007/s10695-018-0555-4. Consultado el 13 de agosto de 2022.
- ↑ Nofouzi, Katayoon; Mirzazadeh, Sorayya; Khordadmehr, Monireh; Madadi, Mohammad Sadegh; Amininia, Soheila; Firouzamandi, Masoumeh; Ranjbar, Vahid Reza (2021-02). «The effects of heat-killed Tsukamurella inchonensis on intestinal morphology and humoral immune responses of broiler chickens». Iranian Journal of Microbiology 13 (1): 81-90. ISSN 2008-3289. PMC 8043829. PMID 33889366. doi:10.18502/ijm.v13i1.5496. Consultado el 13 de agosto de 2022.
- ↑ Pavlov, D.; de Wet, C. M. E.; Grabow, W. O. K.; Ehlers, M. M. (1 de mayo de 2004). «Potentially pathogenic features of heterotrophic plate count bacteria isolated from treated and untreated drinking water». International Journal of Food Microbiology 92 (3): 275-287. ISSN 0168-1605. PMID 15145586. doi:10.1016/j.ijfoodmicro.2003.08.018. Consultado el 13 de agosto de 2022.